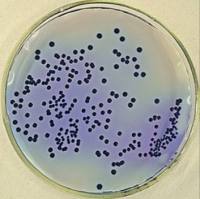
Microdochium sp.

万千商家帮你免费找货
0 人在求购买到急需产品
- 详细信息
- 文献和实验
- 技术资料
- 保存条件:
详询
- 保质期:
三年
- 英文名:
Candida albicans
- 库存:
23
- 供应商:
上海晅科生物科技有限公司
- 规格:
株
菌种详细信息:
菌种名称:白色假丝酵母
拉丁文名称:Candida albicans
其他编号:CMCC98001
培养温度: 25-28℃
用途:科研
分离源:详询
相关培养基:Wort Agar (麦芽汁琼脂)
所购菌种如果为冷冻干燥安瓿,建议采用下列方法恢复培养(供参考)。
一、安瓿管开启
1.用浸过75%酒精的脱脂棉球檫净安瓿管表面。
2.用酒精灯火焰将安瓿管顶端加热。
3.将冷的无菌水滴至加热的安瓿管顶端使玻璃裂开。
4.用无菌的镊子敲开安瓿管顶端。
二、菌种恢复培养
1.用无菌吸管加0.3ml无菌水于安瓿管内,使冻干菌种块溶化呈悬浮状。
2.用无菌吸管取0.1ml悬浮液于己制备好的适宜该菌生长的斜面培养基上,涂匀,在适宜的温度下培养。
三、注意事项
1.全部操作过程需在无菌条件下进行。
2.每支安瓿的菌悬液最多只能接3-4支斜面,避免接种量太少不利于菌种生长。有些菌种经冷冻干燥后,需连续两次继代培养才能正常生长。
3.要求在厌氧条件下培养的菌种,自开封后的全过程,均需按厌氧菌培养条件的要求处理。
4.此安瓿管一次性使用完。
公司专业供应多种菌种,质量保证,价格实惠。如需了解更多白色假丝酵母信息敬请来电咨询!
菌种名称:白色假丝酵母
拉丁文名称:Candida albicans
其他编号:CMCC98001
培养温度: 25-28℃
用途:科研
分离源:详询
相关培养基:Wort Agar (麦芽汁琼脂)
所购菌种如果为冷冻干燥安瓿,建议采用下列方法恢复培养(供参考)。
一、安瓿管开启
1.用浸过75%酒精的脱脂棉球檫净安瓿管表面。
2.用酒精灯火焰将安瓿管顶端加热。
3.将冷的无菌水滴至加热的安瓿管顶端使玻璃裂开。
4.用无菌的镊子敲开安瓿管顶端。
二、菌种恢复培养
1.用无菌吸管加0.3ml无菌水于安瓿管内,使冻干菌种块溶化呈悬浮状。
2.用无菌吸管取0.1ml悬浮液于己制备好的适宜该菌生长的斜面培养基上,涂匀,在适宜的温度下培养。
三、注意事项
1.全部操作过程需在无菌条件下进行。
2.每支安瓿的菌悬液最多只能接3-4支斜面,避免接种量太少不利于菌种生长。有些菌种经冷冻干燥后,需连续两次继代培养才能正常生长。
3.要求在厌氧条件下培养的菌种,自开封后的全过程,均需按厌氧菌培养条件的要求处理。
4.此安瓿管一次性使用完。
公司专业供应多种菌种,质量保证,价格实惠。如需了解更多白色假丝酵母信息敬请来电咨询!
风险提示:丁香通仅作为第三方平台,为商家信息发布提供平台空间。用户咨询产品时请注意保护个人信息及财产安全,合理判断,谨慎选购商品,商家和用户对交易行为负责。对于医疗器械类产品,请先查证核实企业经营资质和医疗器械产品注册证情况。
文献和实验相关实验
假丝酵母菌 假丝酵母菌对热的抵抗力不强,加热至60℃1小时后即可死亡。但对干燥、日光、紫外线及化学制剂等抵抗力较强医学|教育网搜集整理。在假丝酵母菌中80%~90%病原体为白假丝酵母菌10%~20%为光滑假丝酵母菌、近平滑假丝酵母菌热带假丝酵母菌等。
白色念珠菌 白色念珠菌,是一种真菌,通常存在于正常人口腔,上呼吸道,肠道及阴道,一般在正常机体中数量少,不引起疾病,当机体免疫功能或一般防御力下降或正常菌群相互制约作用失调医学教|育网搜集整理,则本菌大量繁殖并改变生长形式(芽生菌丝相)侵入细胞引起疾病。
在暗处发芽的芽苗叶(黄化叶)细胞中的黄色色素体。大小为 2— 4微米。基质中含有类囊体先成结构的片层形成体和质体基粒。白色体在光照射时可形成叶绿素和类囊体,从形成叶绿体这点来看,认为白色体的形成可能是因为从原色素体转化为叶绿体的正常发展过程中在暗条件下暂时受到了抑制。
技术资料暂无技术资料 索取技术资料
白色假丝酵母
¥300 - 1500